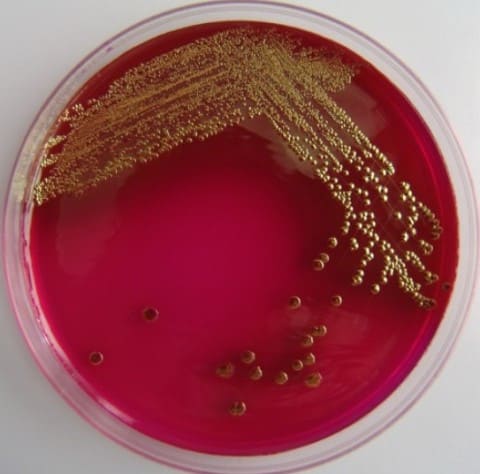
E.coli на питательной среде

Кишечная палочка является довольно распространенным микроорганизмом, вызывающим многочисленные проблемы пищеварительного тракта, мочевыделительной и половой систем у человека, обладающая способностью присутствовать на кожных покровах и слизистых оболочках различных систем организма как вариант нормы.
Кишечная палочка (Escherichia coli или E. coli) – грамотрицательная бактерия (в мазках, окрашенных по Грамму, не окрашивается), относящаяся к Семейству Энтеробактерии, имеющая форму палочки, являющаяся факультативным анаэробом (то есть в основном развивается без наличия кислорода, но в определенных условиях при поступлении кислорода также не теряет своей жизнеспособности). Открыта кишечная палочка была в 1885 году немецким бактериологом Теодором Эшерихом. Палочки имеют закругленные концы, размер от 0,4 до 3 мкм. Некоторые штаммы обладают подвижностью за счет наличия жгутиков, остальные – неподвижны.

Трехмерное изображение кишечной палочки
Оптимальная температура роста кишечной палочки – 37°. E.coli достаточно устойчива во внешней среде, в таких средах как вода, почва, а также испражнениях сохраняет жизнеспособность длительное время. Имеют способность размножаться в пищевых продуктах (например, молоко). При кипячении погибает практически сразу, при температуре 60º в течение 15 минут, дезинфицирующие вещества (растворы хлорамина, формалина и прочее) губительно действуют на кишечную палочку в течение короткого времени.
Различают многочисленные штаммы (разновидности) кишечной палочки, из которых большинство представителей являются безвредными и в нормальных условиях располагаются на слизистых оболочках пищеварительного тракта, причем преимущественно в нижних его отделах.
Кишечная палочка в норме
В нормальных условиях кишечная палочка заселяет кишечник человека (безопасные ее штаммы), среднее количество варьирует от 106 до 108 КОЕ/г содержимого дистального отдела кишечника (КОЕ – колониеобразующая единица). Содержание E.coli в составе другой микрофлоры кишечника не более 1%. В обычных условиях кишечная палочка принимают участие в нормальном функционировании кишечника, синтезирует витамины К, В1, В2, В3, В5, В6, В9, B12. Очень важная функция – конкурентное взаимодействие с условно-патогенной флорой кишечника (ограничение размножения условно-патогенных микроорганизмов).
Непатогенный штамм Nissle 1917 (Mutaflor) применяется с лечебной целью у детей в качестве пробиотика при дисбактериозе кишечника. В кишечнике более полезны так называемые лактозопозитивные кишечные палочки, содержание лактозонегативных не должно превышать 105 КОЕ/г, а гемолитические E. coli и вовсе должны отсутствовать.
Качественный и количественный состав E.coli толстого кишечника у здоровых людей разных возрастов, как у детей до года, так и старше 60 лет, не имеет различий. Для типичных E.coli это 107-108 КОЕ/г фекалий, E.coli лактозонегативные < 105, гемолитические кишечные палочки в норме отсутствуют. Состав остальной флоры кишечника отличается по возрастам по другим параметрам.
Отклонения в содержании непатогенных штаммов кишечной палочки в кишечнике называются дисбактериозом и имеют несколько степеней.
Степени микробиологических нарушений E. coli при дисбактериозе кишечника
1-я степень микробиологических нарушений: типичных эшерихий до 106-105 КОЕ/г, возможно повышение содержания типичных эшерихий до 109- 1010 КОЕ/г
2-я степень микробиологических нарушений: повышение содержания гемолитических эшерихий до концентрации 105-107 КОЕ/ г
3-я степень микробиологических нарушений: обнаружение E.coli в ассоциации с другими условнопатоген-ными микроорганизмами в концентрации 106-107 КОЕ/г и выше
Патогенные кишечные палочки
Выделяют более 100 штаммов патогенной кишечной палочки, которые объединены в 4 класса:
- энтеропатогенные E. Coli (ETEC);
- энтеротоксигенные E. coli;
- энтероинвазивные E.coli (EIEC);
- энтерогеморрагические E.coli (EHEC).
Морфологически они ничем не отличаются. Особенностью патогенных штаммов является способность при попадании в организм человека продуцировать энтеротоксины (термостабильные или стойкие к высоким температурам и термолабильные или быстроразрушающиеся), за счет которых возникает диарея. Например, E.coli O157:H7, которая продуцирует подобные токсины. Помимо этого для каждой группы характерны свои особенности симптомов заболевания.
Поражение кишечной палочкой желудочно-кишечного тракта
Эшерихиозы – заболевания, возникающие в результате попадания в организм патогенных штаммов кишечных палочек, характеризующиеся интоксикацией и поражением преимущественно желудочно-кишечного тракта, но иногда поражающих мочевыводящую систему, желчевыводящие пути и другие органы с возможностью у некоторых пациентов возникновения сепсиса.
Механизм заражения алиментарный, путь фекально-оральный. Факторами передачи являются загрязненная вода и пищевые продукты. В большинстве своем заболевают дети раннего возраста.
Инкубационный период (с момента заражения до возникновения клинической картины) от 48 до 72 часов чаще всего (реже сокращается до 1 дня или продлевается до 10 суток).
Эшерихиозы, вызванные энтеропатогенной кишечной палочкой: чаще поражаются новорожденные и дети первого года жизни. Являются причиной диареи в роддомах. У маленьких пациентов рвота или срыгивание, частый жидкий стул без патологических примесей (кровь), выраженные боли в животе, беспокойство ребенка, отказ от еды, нарушенный сон.
Эшерихиозы, вызванные энтеротоксигенной кишечной палочкой: данные штаммы обладают способностью прикрепляться к клеткам эпителия кишечника, существенно нарушая их функцию и вызывая сильную водянистую диарею. Также часто проявляются у детей, взрослых и при так называемой «диарее путешественников». У пациентов водянистый стул, без крови, позывы на рвоту, болезненность в животе.
Эшерихиозы, вызванные энтерогеморрагической кишечной палочкой: вызывает геморрагический колит, в тяжелых случаях проявления гемолитико-уремического синдрома (ГУС). При геморрагическом колите у пациентов высокая температура до 39-39,5º, симптомы интоксикации, схваткообразные (или спастические) боли в животе, а также появление водянистого стула с примесью крови. Осложнениями могут быть развитие анемии гемолитического характера, острой почечной недостаточности и геморрагического синдрома.
Гемолитико-уремический синдром (ГУС) – специфический синдром, для которого характерна триада симптомов – гемолитическая анемия, острая почечная недостаточность и критическое падение количества тромбоцитов. Возникает чаще в детской возрастной группе от 6 мес до 4х лет, а также у пожилых пациентов. В 90% случаев встречается при кишечных инфекциях (E.coli, продуцирующая веротоксин, Shigellae и прочие). Причина – поражение клеток эндотелия сосудов. Возникает в среднем через неделю после перенесенной инфекции. Клинически может появиться лимонного цвета желтуха, нарушение оттока мочи, отеки, кровоизлияния на коже и другие тяжелые проявления. Однако при появлений данной симптоматики можно говорить о развернутой клинической картине ГУС. Ранними же его признаками являются лабораторные: появление белка в моче - протеинурия, появление эритроцитов в моче – эритроцитурия, повышение креатинина сыворотки крови, а также снижение эритроцитов и гемоглобина в крови.
Эшерихиозы, вызванные энтероинвазивной кишечной палочкой: по биохимическим свойствам энтероинвазивные E.coli сходны с шигеллами – возбудителями дизентерии, в частности обладают способностью проникать в клетки эпителия определенного отдела кишечника (ободочной кишки) и там размножаться. Этим объясняется и появление определенной симптоматики при таких эшерихиозах: боли в подвздошной области слева (слева внизу живота), обильный водянистый стул с примесью крови. В отличие от дизентерии, чаще это все-таки водянистый стул, а не скудный со слизью и кровью (как при шигеллезе).
Обобщая вышесказанное, понятно, что нет единой специфической картины эшерихиозов, жалобы пациентов могут быть различными: температура, рвота, водянистый стул без примесей и с кровью, боли в животе разной локализации ноющего характера.
Поражение кишечной палочкой мочевыводящих путей
Механизм заражения чаще связан с непосредственным поступлением кишечной палочки из толстого кишечника при несоблюдении или недостаточном соблюдении личной гигиены, а также при использовании нетрадиционных способов сексуальных контактов (с применением анального секса).
До 80-85% инфекций мочевыводящих путей связано с E. coli. Более 60% острых процессов при воспалении предстательной железы связано именно с этим возбудителем. Подавляющее большинство хронических простатитов связано с кишечной палочкой.
Клинические формы поражения мочевыводящей системы различны. Это могут быть уретриты, циститы, пиелонефриты, простатиты.
Поражение кишечной палочкой половой системы
Большая часть воспалительных процессов в придатке яичка (эпидидимит), воспаление яичка (орхит), а также их сочетанное поражение, воспаление яичников (аднекситы) связано именно с кишечной палочкой.
Диагностика инфекций, вызванных кишечной палочкой
1) Бактериологический метод – посев биологического материала на специальные питательные среды. Материалом служат при инфекциях кишечника – испражнения и рвотные массы, при инфекциях мочевыделительной системы – моча, при инфекциях половой системы – мазки и соскобы со слизистых половых органов. После идентификации возбудителя проведение антибиотикограммы (определение чувствительности к антибиотикам).
При отклонении содержания кишечной палочки в испражнениях ставят определенную степень микробиологических нарушений (дисбактериоза) или обнаруживают патогенные штаммы кишечной палочки. Наличие E.coli в моче называется бактериурией. При отсутствии симптомов диагноз выставляется при появлении микроорганизмов в количестве 105 и выше КОЕ/мл мочи. Если их количество меньше, то считают это признаком контаминации (загрязнение мочи при заборе). Если же симптомы болезни явно выражены, то достаточно 102-104КОЕ/мл мочи.
E.coli на питательной среде
2) Общеклинические методы исследования (копрограмма, общий анализ мочи, крови, биохимическое исследование крови и другие) являются дополнительными.
3) Инструментальные методы исследования (ректороманоскопия, урография, УЗИ и другие).
Общие принципы лечения инфекций, вызванных кишечной палочкой
1. Организационно-режимные мероприятия (госпитализация по клиническим показаниям), диетный режим согласно поражению определенных систем организма (стол № 4 при поражении кишечника, стол № 7 при поражении мочеполовой системы).
2. Медикаментозная терапия включает этиотропную терапию (антибиотики, бактериофаги), патогенетическую терапию (чаще инфузионную), посиндромальную терапию.
Антибактериальная терапия должна проводиться с учетом антибиотикограммы выделенной кишечной палочки. Чаще выявляется чувствительность кишечной палочки к препаратам группы фторхинолона (ципрофлоксацин, левофлоксацин), амоксициллину, нитрофуранам, и другим. И сам препарат, и его дозу, и продолжительность курса лечения назначается только врачом. Самолечение в целях профилактики развития устойчивости кишечной палочки к антибиотикам недопустимо!
Также в отношении E.coli достаточно эффективны бактериофаги (применяются при поражении кишечника) – это бакериофаг коли жидкий, интестибактериофаг, колипротейный бактериофаг, пиобактериофаг комбинированный жидкий, пиобактериофаг поливалентный комбинированный жидкий и другие.
Специально полученные штаммы кишечной палочки входят в состав некоторых лекарственных препаратов, которые используются при дисбактериозе с недостатком E. coli в кишечнике (хелак форте, бификол, колибактерин). Также при дисбактериозе с избыточным ростом кишечной палочки назначаются пробиотики (линнекс, аципол, ацилакт, лактобактерин, бифиформ, бифистим и другие).
Патогенетическая терапия сводится к проведению инфузионной терапии - введения в кровоток различных растворов определённого объёма и концентрации с целью дезинтоксикации и восполнения потерь жидкости при поражении желудочно-кишечного тракта, а также детоксикации организма при поражении почек.
Посиндромальная терапия назначается врачом индивидуально в зависимости от ведущего синдрома заболевания.
Особенности лечения детей и беременных: в данных группах пациентов схемы лечения начинаются с использованием биактериофагов и пробиотиков и только при неэффективности данных препаратов назначаются антибактериальные препараты с учетом возраста, степени поражения.
Профилактика инфекций, вызванных кишечной палочкой
На первом месте при профилактике стоит соблюдение личной гигиены и правил тепловой обработки и хранения пищевых продуктов, мытье овощей и фруктов, а также недопущение употребления в пищу воды из неизвестных источников.
Врач инфекционист Быкова Н.И.




Комментарии
Похожая ситуация у меня была у сына - кишечная палочка и энтерококк - вызвали у него острый цистит. Его лечил врач уролог - лечение было назначено быстро и своевременно - курс лечения был 10 дней - Левофлоксацин 500 мг - один раз в день + Орнидазол 500 мг - два раза в день - и принимать всё это с линексом ровно 10 дней. Вот и всё лечение. Сейчас он чувствует себя прекрасно ни кишечки ни энтерококков всё в норме.......... .....
Кишечная палочка это такая дрянь! Изза которой куча проблем с жкт и здоровьем
Как ее вылечить? кроме бактериофага есть что-то эффективное?